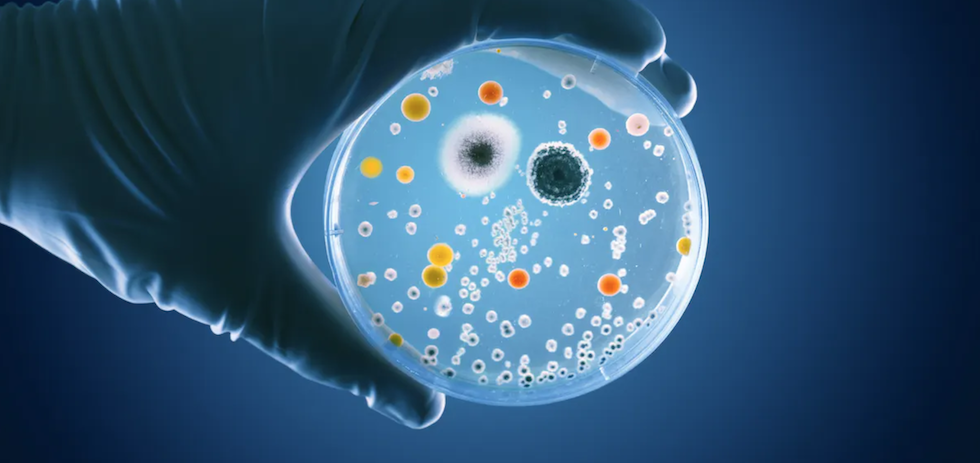

En casi año y medio de covid-19, las medidas restrictivas para frenar la pandemia han variado al son de la incidencia del virus. Pese a que hemos logrado adelantar a los Estados Unidos en el número de vacunaciones diarias, nos encontramos en plena quinta ola de la pandemia.
Lo positivo es que, en este periodo de tiempo, se han desarrollado diferentes vacunas con una efectividad más que probada, y se ha investigado sobre diferentes factores que pueden influir tanto en el contagio como en la clínica de la covid-19.
En este sentido, y al igual que ocurre con otras enfermedades, cada vez se está prestando más atención a la posible implicación de la microbiota en la covid-19.
El órgano olvidado
La microbiota intestinal (o microbioma intestinal) se podría definir como una compleja comunidad de microorganismos, principalmente bacterias, que residen en nuestro intestino y que puede alcanzar un peso de aproximadamente 2 kg.
Cabe destacar que la microbiota intestinal juega un papel relevante en la digestión de alimentos (participando en la extracción de nutrientes) y en la síntesis de algunos nutrientes, produce diferentes metabolitos y regula la función inmune. Su composición (riqueza y variedad de microorganismos) se ve afectada por factores como los hábitos dietéticos o el estilo de vida de una persona (actividad física). Y los cambios pueden tener consecuencias en la salud.
Además, también se han descrito alteraciones de la microbiota intestinal (disbiosis) asociadas a enfermedades como la obesidad, la diabetes tipo 2 o la enfermedad del colon irritable.
Microbiota pulmonar: más allá del intestino
Pero no solo existe microbiota en el intestino. El pulmón también cuenta con bacterias, principalmente bacteroidetes, firmicutes y proteobacteria.
Además, se sabe que existe una especie de comunicación cruzada entre el intestino y el pulmón (eje intestino-pulmón) mediado, al menos en parte, por la microbiota. Así, se sabe que los metabolitos que se producen cuando existe una inflamación en el intestino (endotoxinas) pueden afectar al pulmón. Y viceversa: las infecciones respiratorias podrían afectar a la composición de la microbiota intestinal.
En este sentido, dado que los síntomas gastrointestinales (vómitos, dolor abdominal y/o diarrea) suelen ser relativamente frecuentes en pacientes con covid-19, se ha propuesto que dichas afectaciones podrían derivar del eje intestino-pulmón. No hay que olvidar que tanto el epitelio pulmonar como el intestinal forman parte del sistema inmune de las mucosas.
La relación intestino-pulmón puede abrir la puerta a futuras investigaciones e intervenciones que permitan hacer frente al virus de manera más efectiva.
Microbiota, eje intestino-pulmón y covid-19
A pesar de que el SARS-CoV-2 afecta principalmente al tejido pulmonar, a día de hoy se sabe que es capaz de infectar el tracto gastrointestinal. Así, aunque el principal síntoma de la covid-19 es el síndrome de dificultad respiratoria aguda, también podría interactuar con la microbiota intestinal, aumentando la producción de intermediarios proinflamatorios.
De hecho, se han encontrado grandes cantidades de virus replicantes (principalmente en células epiteliales) en biopsias de intestino delgado y colon de pacientes con covid-19.
En este escenario, se ha sugerido que la mayor severidad de la covid-19 en sujetos con obesidad y/o diabetes tipo 2 podría deberse a la disbiosis característica de dichas enfermedades metabólicas. En estos casos, la propia disbiosis podría dar lugar a una respuesta inflamatoria descontrolada del sistema inmune a la infección por SARS-CoV-2, produciendo una liberación masiva de citoquinas proinflamatorias conocida como “tormenta de citoquinas”.
Por otro lado, se ha observado una correlación negativa entre síntomas gastrointestinales prolongados y la riqueza y diversidad de la microbiota intestinal en pacientes con covid-19. Esto podría guardar relación con una respuesta inmune alterada, que ralentizaría la eliminación de SARS-CoV-2.
A esto se le suma que, en pacientes con covid-19 y síndrome de dificultad respiratoria aguda, se ha identificado la presencia de microbiota intestinal dentro de los pulmones. Esto sugiere que la covid-19 podría alterar el eje intestino-pulmón, dando lugar a una retroalimentación entre el estado inflamatorio del intestino y el pulmón.
De hecho, un reciente estudio llevado a cabo en un hospital de Ámsterdam concluyó que tanto la carga bacteriana como la presencia de microbiota intestinal en el pulmón son predictores del desenlace de la enfermedad en pacientes críticos con covid-19.
En ese mismo estudio encontraron también que la microbiota pulmonar de pacientes de covid-19 era diferente en pacientes con o sin síndrome de dificultad respiratoria aguda. Todo apunta a que la diferencia estaría causada por una mayor presencia de microbiota intestinal en el pulmón de los pacientes con complicaciones.
La microbiota como posible diana terapéutica en la covid-19
A pesar de que todavía no se conocen en profundidad los mecanismos implicados en esta relación intestino-pulmón-covid-19, los resultados disponibles apuntan a su implicación en el desarrollo/severidad de la enfermedad. En este sentido, se considera que las intervenciones capaces de modular/recuperar la composición de la microbiota intestinal podrían ayudar a reducir la severidad de la covid-19.
De hecho, a día de hoy se están llevando a cabo numerosos estudios clínicos sobre la potencial utilidad de probióticos, prebióticos y simbióticos en la covid-19. A pesar de que los resultados disponibles de estas intervenciones son aún escasos, ya podemos afirmar que la recuperación de la microbiota intestinal favorece una mayor producción de metabolitos con efecto antiinflamatorio por parte de bacterias comensales.
![]()

Normas de participación
Esta es la opinión de los lectores, no la de este medio.
Nos reservamos el derecho a eliminar los comentarios inapropiados.
La participación implica que ha leído y acepta las Normas de Participación y Política de Privacidad
Normas de Participación
Política de privacidad
Por seguridad guardamos tu IP
216.73.217.23